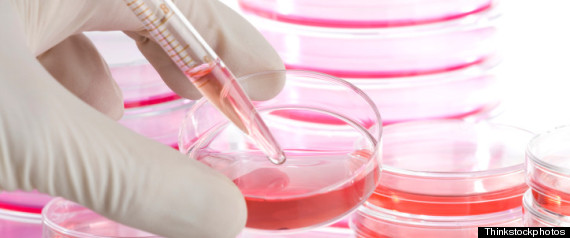
stamina.jpg stamina.jpg

Al direttore – Luigi Manconi sul Foglio del 9 aprile scorso affronta una questione delicata. E’ vero: il caso della piccola Sofia solleva dilemmi che non possiamo e dobbiamo sottovalutare. Proprio per questo non bisogna suscitare false speranze e illusioni. Non si deve smarrire il ricordo di quello che accadde quando venne autorizzato il cosiddetto metodo Di Bella: ad andarci di mezzo furono tantissimi malati, che abbandonarono le terapie per affidarsi a quel “metodo” che non li guarì e contribuì ad aggravare le loro condizioni. Il ministro della Salute Balduzzi ha disposto che il metodo “Stamina” continui a essere praticato, con buona pace della comunità scientifica che respinge quel metodo, valutandolo inutile se non dannoso. Si obietta che esiste una sfera che sfugge al raziocinio, nella quale rientrano le cosiddette “cure compassionevoli”, metodi la cui validità scientifica non è comprovata. Balduzzi ha stabilito che il metodo “Stamina” sia somministrato anche se è un trattamento a base di cellule staminali non identificabili, prodotto in laboratori non qualificati, la cui efficacia non è provata da nessun protocollo. Si crea inoltre un precedente: ora si potrà respingere la richiesta di chi esigerà da parte dello stato “la cura che non esiste” che ognuno riterrà più giusta, a prescindere dalla sua inefficacia e dunque pericolosità? Lo stato, e tantomeno un ministro dimissionario, non possono alimentare false speranze. Farlo non è compassione; è una forma di crudeltà, per quanto possa essere involontaria o animata da migliori intenzioni. La scienza e la medicina esigono che si operi sulla base di ipotesi razionali Mi auguro che nell’esame di questo decreto si proceda avendo almeno il conforto di esperti e ricercatori; e che si predisponga un calendario per le loro audizioni

L’Associazione Luca Coscioni è una associazione no profit di promozione sociale. Tra le sue priorità vi sono l’affermazione delle libertà civili e i diritti umani, in particolare quello alla scienza, l’assistenza personale autogestita, l’abbattimento della barriere architettoniche, le scelte di fine vita, la legalizzazione dell’eutanasia, l’accesso ai cannabinoidi medici e il monitoraggio mondiale di leggi e politiche in materia di scienza e auto-determinazione.